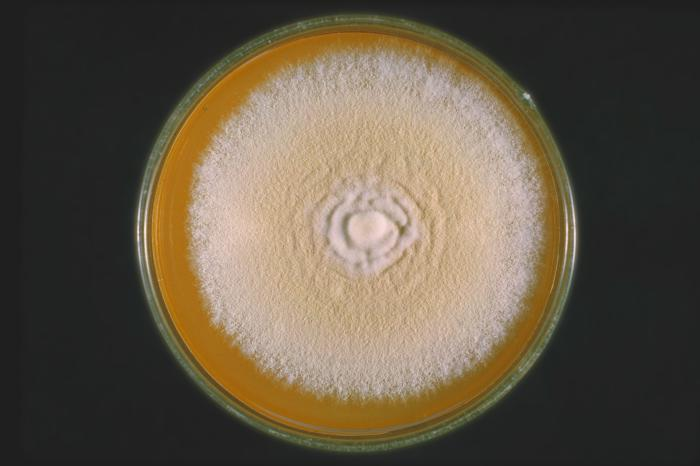

Стригущий лишай (трихофития) у собак
ОГЛАВЛЕНИЕ
Введение…………………………………………………………………………...3
Глава 1. Стригущий лишай (трихофития) у собак…………...…………………5
- Определение болезни. Эпизоотические данные. Характеристика возбудителей трихофитии у собак………………………………………….…....5
- Патогенез. Клинические признаки трихофитии у собак…….................9
Глава 2. Диагностика. Лечение. Профилактика и меры борьбы трихофитии у собак………............................................................................................................11
Глава 3. История болезни щенка с диагнозом трихофития…………………...18
Заключение……………………………………………………………………….32
Список литературы………………………………………………………………34
ВВЕДЕНИЕ
Актуальность работы. Перед отечественной ветеринарией и микологией остро стоит вопрос о совершенствовании существующих и разработке новых методов диагностики дерматомикозов, а также индикации возбудителей микозов в объектах внешней среды. Изменение экологического фона в ряде республик и областей, процессы урбанизации и связанные с ними изменения структуры и границ нозоареалов этих заболеваний, вносят серьезные изменения в эпидемиологию и влияют на характер клинического течения современных зоонозных дерматомикозов у животных и их владельцев. Это способствует распространению зоонозных дерматомикозов в различающихся по климатогеографическим, экономическим и экологическим условиям ареалах страны [15].
Изучению проблем трихофитии, обусловленной зоофильнымн трихофитонами, посвящены исследования Н.А. Медведевой (1968), П.Н. Пестерева (1988), Э.В Чистяковой (1992). В них освещены особенности морфологии грнбов-возбудителей, вопросы эпидемиологи, патогенеза, клиники и лечения данных микозов. Однако за последнее десятилетие изменились спектр возбудителей и клинические проявления трихофитии, что указывает на необходимость дальнейшего изучения этнологического своеобразия и клинических особенностей последней. Проблеме патогенеза трихофитии, в том числе и изучению процессов иммуногенез при данном микозе, посвящены исследования Ю.А. Медведева (1989) и других авторов [8].
Характерной особенностью всех дерматомикозов и трихофитии у собак, в частности, является видоизменение микробиоты. Если раньше наиболее частыми возбудителями дерматомикозов были антропофильные грибы, то сейчас на их долю приходится не более 1% микобиоты. Основными возбудителями микроспории и трихофитии стали зоофильные грибы. Для трихофитии - это Trichophyton verrucosum и T. mentagrophytes var. gypseum [5].
Цель работы: изучить особенности трихофитии у собак, составить историю болезни щенка с диагнозом трихофития.
Предмет работы: трихофития.
Объект работы: щенок с диагнозом трихофития.
Задачи работы:
1. Дать понятие трихофитии, эпизоотические данные, характеристику возбудителей трихофитии у собак.
2. Рассмотреть патогенез и клинические признаки трихофитии у собак.
3. Изучить методы диагностики, лечение и профилактику трихофитии у собак.
4. Составить историю болезни курируемого щенка с диагнозом трихофития.
Методы исследования: анализ литературы по данной теме, синтез, абстрагирование, обобщение, наблюдение, медицинское исследование.
Объем и структура работы. Курсовая работы изложена на 37 страницах печатного текста. Курсовая состоит из введения, трех глав, включающих параграфы, заключения и списка использованной литературы. Список литературы включает 40 источников, из них 34 отечественных и 6 зарубежных авторов.
ГЛАВА 1. СТРИГУЩИЙ ЛИШАЙ (ТРИХОФИТИЯ) У СОБАК
- Определение болезни. Эпизоотические данные. Характеристика возбудителей трихофитии у собак
Трихофития - распространенное среди дерматомикозов собак заболевание, основными возбудителями которой являются Trichophyton verrucosum и Trichophyton mentagrophytes var. gypseum. Трихофития - природно-очаговая инфекция, эпидемические особенности и периодичность вспышек которой зависят от географических, экологических и ряда других факторов [11].
Источником инфекции является больной человек, животные или почва. Возбудители устойчивы к действию окружающей среды, их споры в высушенном состоянии сохраняют жизнеспособность в течение нескольких месяцев. Передача происходит при контакте с инфицированным человеком или животным либо через предметы обихода. В возникновении патологических процессов на коже определённую роль играют изменения рН среды. В современных природных условиях трихофития имеет ряд характерных особенностей - изменился видовой состав возбудителей. Основным возбудителем является фавиформный трихофитон, удельный вес которого составляет 80-85 % [7].
Возбудитель данной болезни гриб, относящийся к роду Trichophyton. Мицелий гриба не отличается устойчивостью. Споры же весьма устойчивы: в помещениях сохраняются 4-10 лет, на шерсти животных - 12-15 месяцев, в почве - 1,5 года, в навозе и навозной жиже - 8 месяцев, патологическом материале (кожа, волосы) при высушивании - более двух лет. Клетки грибов состоят из оболочки протоплазмы, ядра и ряда включений. Имеют в своем составе жир, витамины, гликоген и кристаллы органических солей. В естественных условиях дерматофиты образуют мицелий, распадающийся на артроспоры, а в культуре на питательных средах - обычно обильный и разнообразный рост. Споры образуются внутри и вне мицелия. Большинство грибов являются аэробами [19].
Tr. mentagrophytes - споры мелкие - 3-5 мкм. Культуры растут быстро, колонии появляются на 3-5-й день, зрелые на 14-16-й день. Колонии белые, кремовые, темно-желтые, могут быть порошистые. Бархатистые. Встречаются спиральные окончания спор. Микроконидии многочисленные, округлые или овальные. Артроспоры отсутствуют. Микроконидии булавовидной формы (рис.1) [21].
Рис.1. Trichophyton mentagrophytes var. gypseum.
Tr. verrucosum - крупноспоровые грибы от 5-ти до 8-ми мкм, поражают волос по типу эктотрикс (рис. 2). Их элементы в большинстве случаев располагаются вне волоса, споровой чехол находится у основания волоса и хорошо выражен. Грибы растут медленно на сусло-агаре или агаре Сабуро. Зрелые колонии появляются на 15-25 день. Колонии белые, серые, кожистые, возвышенные или плоские, складчатые или бугристые, растущий край ровный, лучистый, паутинистый. Мицелий ветвящийся, микроконидии (алейрии) овальные, грушевидные, артроспоры округлой формы. Хламидоспоры терминальные или интеркалярные. Микроконидии удлинённые [34].

Рис.2. Trichophyton verrucosum
Поражения чаще всего обнаруживаются на коже головы (возле носа, глаз), конечностей, шеи; могут быть и на других местах. На пораженных участках вначале наблюдается шелушение кожи и обламывание волос, вследствие чего образуются плешины. Затем на них появляются маленькие, быстро засыхающие пузырьки, покрывающиеся серовато-белыми сухими корками. Участки поражения постепенно увеличиваются, расширяясь к периферии. У больных животных понижается прирост массы тела, снижается качество шерсти и уровень естественной резистентности [10].
Носителями патогенных дерматомицетов являются мыши, крысы и другие грызуны. У собак и кошек стригущий лишай возникает и легко распространяется при нарушении зоогигиенических правил содержания, поэтому особенно часто он встречается у бездомных, бродячих животных. Такие животные представляют наибольшую опасность и для человека (прежде всего для детей). Неблагоприятные погодные условия и поверхностные повреждения кожи способствуют проявлению стригущего лишая [25].
Наиболее часто микроспория и трихофития поражают молодых животных - щенков и котят в возрасте до 1 года. Распространению заболеваний способствует нарушение зоогигиенических и ветеринарно-санитарных правил содержания, кормления и эксплуатации животных (нарушение нормального микроклимата, скученное содержание, перемещения и перегруппировки животных, а также массовая контактная экспертиза во время выставочных мероприятий) [27].
В последние 30-40 лет зооантропонозную трихофитию с атипичной формой локализации патологического процесса не регистрировали. Преимущественным (97,9%) возбудителем заболевания является Trichophyton verrucosum. В 2011 году на территории Российской Федерации было зарегистрировано 2,3 случая трихофитии на 100000 собак. Наиболее часто трихофития встречается в Южном федеральном округе (показатель заболеваемости составил 5,7 и 6,7 на 100000 собак в 2010 и 2011 гг. соответственно). К регионам с высокой заболеваемостью трихофитией у собак относятся республики Башкортостан, Дагестан, Кабардино-Балкария, Ингушетия, Саха (Якутия). На территории Северо-Западного территориального округа Российской Федерации (РФ) трихофития у собак регистрируется спорадически, хотя в последние годы отмечается тенденция к постепенному росту заболеваемости. Этому способствуют активная миграция населения из южных регионов России и Средней Азии, ослабление ветеринарного контроля, слабый уровень знаний о клинической картине трихофитии специалистов-дерматологов и врачей других специальностей [19].
- Патогенез. Клинические признаки трихофитии у собак
Возбудители трихофитии - антропофильные грибы, поражающие гладкую кожу, волосы и ногти. При обитании на коже воспалительные явления неглубокие, нерезко выраженные. Грибы располагаются в сердцевине волоса. Инфильтративно-нагноительная трихофития вызывается грибами, паразитирующими на человеке и животных, т.е. относящимися к группе зооантропофильных. По характеру и свойствам культур на питательных средах они классифицируются как Tr. mentagraphytes (var. gipseum), Tr. verrucosum (var. faviforme). Располагаясь по наружной поверхности волоса и образуя как бы чехол вокруг него. В зависимости от величины спор и их биологических особенностей выделяют мелкоспоровую разновидность, паразитирующую у мелких домашних животных, мышей, крыс, кроликов, морских свинок. Крупноспоровая разновидность обитает у крупных домашних животных -собак, лошадей, коров, телят, овец [39].
Трихофитоны размножаются в тканях, содержащих роговое вещество - керотин, который имеется в роговом слое эпидермиса кожи и в волосе. Возбудитель выделяет токсины и кератолитические ферменты, вызывающие поверхностное воспаление и разрыхление рогового слоя кожи. При условиях, благоприятных для развития, возбудитель проникает к устью волосяных фолликулов и в шейку волоса, разрушает кутикулу, внутреннее волосяное влагалище, корковое вещество, что ведет к нарушению питания волоса и его выпадению. В месте поражения развивается гиперкератоз [2].
Клинические признаки. Инкубационный период длится от недели до месяца. Заболевание протекает хронически и выражается в появлении на коже небольших безволосых пятен округлой формы, покрытых чешуйками и корочками асбестово-серого цвета (рис.3). Чаще всего поражается кожа головы, шеи, конечностей. В запущенных случаях множественные пятна могут сливаться и захватывать значительные участки тела. Зуд отсутствует или слабо выражен [14].

Рис.3. Трихофития у щенка.
При глубокой форме трихофитии у собак происходит нагноение волосяных мешочков, под корками скапливается много гноя. Стригущий лишай может поражать и когти (онихомикоз). В этом случае они становятся толстыми и деформируются. В легких случаях заболевание протекает без зуда. На пораженных местах могут появиться корочки и струпья, которые позже начинают мокнуть. Собака лижет их и пытается чесать. Иногда отмечается обширное поражение кожи. В легких случаях заболевание приводит к выпадению волос и локальному шелушению кожи [18].
ГЛАВА 2. ДИАГНОСТИКА. ЛЕЧЕНИЕ. ПРОФИЛАКТИКА И МЕРЫ БОРЬБЫ ТРИХОФИТИИ У СОБАК
В последние годы отмечается клиническое многообразие трихофитии у собак, наличие атипичных и стертых клинических форм, что, в свою очередь, затрудняет своевременную диагностику. Атипичные формы заболевания необходимо дифференцировать с простым лишаем у собак, розовым лишаем Жибера, псориазом, микробной и себорейной экземой, атопическим дерматитом, гидраденитом, хронической пиодермией, вульгарным сикозом [20].
Поверхностная, инфильтративная и нагноительная формы трихофитии представляют собой последовательные стадии развития патологического процесса. Клиническая картина поверхностной трихофитии достаточно характерна. У собак появляются один или несколько очагов розового цвета, округло-овальной формы, с четкими границами, шелушением; по периферии очагов могут располагаться фолликулярные узелки. При инфильтративной форме очаги поражения резко очерчены, кожа гиперемирована, отечна, инфильтрирована и несколько возвышается над общим уровнем, могут встречаться единичные пустулы, корочки гнойно-геморрагического характера. При развитии процесса на коже часто поражаются пушковые волосы, что приводит к развитию остиофолликулитов; при поражении головы или области бороды и усов волосы обламываются. Нагноительная форма трихофитии у собак чаще развивается на волосистой части головы либо в зоне роста бороды и усов вследствие дальнейшего прогрессирования микотического процесса. Гиперемия кожи в области очага поражения усиливается, появляются множественные фолликулиты, сливающиеся в массивный инфильтрат, значительно выступающий над поверхностью кожи и болезненный при пальпации. Как правило, при нагноительной форме трихофитии наблюдается увеличение регионарных лимфатических узлов, повышение температуры тела, нарушение общего состояния животного. При инфильтративно-нагноительной форме трихофитии волосы в очагах поражения очень легко эпилируются. Зачастую при развитии рубцовых изменений кожи волосы полностью не восстанавливаются [14].
Клинический диагноз трихофитии у собак должен быть подтвержден данными лабораторных исследований. В обычной клинической практике при трихофитии ограничиваются микроскопическим и культуральным методами исследования зараженного материала. Перед микроскопией пораженные объекты (кожные чешуйки, волосы, покрышки пузырьков) предварительно обрабатывают 10%-ным раствором едкого калия или 25%-ным раствором натрия гидроксида для просветления препарата. Поэтому часто этот метод диагностики называют КОН-тестом. Микроскопическая идентификация микромицетов напрямую в клиническом образце является быстрым диагностическим методом, однако наличие ложноотрицательных результатов более чем в 15% случаев указывает на недостаточную специфичность и чувствительность метода. Данным методом можно выявить наличие дерматомицетов, но идентификация их не представляется возможной. Также этот тест ограничивает субъективная оценка врача-лаборанта. Так, чувствительность прямой микроскопии при грибковом поражении головы животного, по данным ряда авторов, варьирует от 67 до 91% [31].
С целью повышения специфичности и чувствительности разработан ряд методик, позволяющих просто и быстро идентифицировать различные виды микромицетов. В микологических лабораториях просветление препаратов для микроскопического исследования проводят 15-30%-ным раствором КОН, в который добавляют 5-10%-ный раствор темно-синих чернил фирмы «Паркер» (Parkers Superchrome Blue-Black Ink). При этом методе гифы и споры дерматомицетов окрашиваются в голубой цвет [25].
В последнее время разработан и внедрен в практику новый метод микроскопии нативных препаратов с окраской калькофлюором белым. Этот реагент в качестве отбеливающего средства используется в текстильной и бумажной промышленности. Совместное применение калькофлюора белого с КОН позволяет выявлять как молодые, так и зрелые гифы дерматомицетов. Применение метода окраски калькофлюором белым при микроскопической диагностике дерматомикозов позволяет на 10% увеличить выявляемость грибковой инфекции по сравнению со стандартным КОН-методом. Краска флуоресцирует в ультрафиолетовом свете (при коротковолновом облучении). Визуализация проводится под флуоресцентным микроскопом [40].
Для окрашивания гистологических срезов волос широко применяют метод PAS (периодическая кислотная реакция) окрашивания. Последний мало отличается от процедуры окрашивания тканевых срезов и сопровождается окраской определенных гликанов (полисахаридов), находящихся в клеточной стенке дерматомицетов. С целью выявления наиболее информативного метода диагностики J. Weinberg и соавт. сравнили четыре диагностических теста, а именно: микроскопический, культуральный, метод люминесцентной микроскопии с белым калькофлюором и биопсии ногтя. Авторы установили чувствительность микроскопии в 80%, культурального метода в 59% и биопсии ногтя - в 92% по сравнению с люминесцентной микроскопией с белым калькофлюором, который был выбран в качестве основного метода. Преимуществом всех вышеперечисленных методик микроскопии является их быстрая и простая техника проведения, однако они не дают возможность идентифицировать вид микромицетов [12].
Для установления видовой принадлежности возбудителя проводится посев материала на питательную среду Сабуро с последующей идентификацией выделенной культуры. Известен способ выделения дерматомицетов на плотной среде Сабуро с селективными добавками в виде пенициллина (20000 ЕД) или стрептомицина (40000 ЕД), гентамицина (0,005 г/л), левомицетина (0,16 г/л). Недостатком данной культуральной среды является медленный рост выделяемых культур, что обуславливает длительные сроки диагностики. С целью сокращения сроков роста культур рядом авторов предложены различные модификации состава среды Сабуро. Описан способ культивирования дерматофитов в жидкой среде, содержащей кератин [28].
З.Р. Хисматуллиной и соавт. был разработан способ идентификации дерматомицетов с использованием культуральной среды Сабуро с гидролизатом кератина, позволяющий сократить сроки выделения грибов из материала больного животного. Увеличение скорости роста культур микромицетов происходит при содержании в питательной среде гидролизата кератина выше 20 г/л. Высев дерматофитов предлагаемым способом позволяет проводить идентификацию для Tr. mentagrophytes var. gypseum на 4-5-й день, для Tr. verrucosum - на 7-8-й день [33].
Одной из попыток усовершенствовать и обеспечить массовую культуральную диагностику дерматомицетов является разработка тестовой среды для дерматофитов (DTM, delmatophyte test medium), содержащей агар Сабуро с антибиотиками, циклогексимидом и индикатором роста культуры дерматофитов. Внедрение среды DTM произвело на свет концепцию «офисного культивирования», при котором появилась возможность наблюдать рост в одноразовых чашках не в специальной лаборатории, а непосредственно в кабинете врача-ветеринара, поскольку рост культуры идет при комнатной температуре [34].
Даже при соблюдении всех правил сбора материала, при наличии оборудования и высоком профессионализме сотрудников лаборатории число выявляемых положительных результатов культурального исследования весьма невелико. Культуральный метод - это специфический диагностический тест, который требует до 8 недель времени, прежде чем результат будет получен. Однако при этом, по данным зарубежной литературы, доля положительного культурального исследования едва достигает 50%, в отечественных исследованиях возбудитель не удается выделить и в 64% случаев. Это обусловлено техническими погрешностями (нарушение правил забора материала, его транспортировки и т.д.), но чаще всего - проведением предшествующей (как правило, местной) антифунгальной терапии у собак их владельцами. Владельцы собак часто занимаются их самолечением с применением наружных антимикотических средств, что приводит не только к изменению клинической картины, но и, естественно, к появлению ложноотрицательных результатов исследования при дерматофитиях [30].
Некоторыми авторами неоднократно предлагались разные диагностические подходы, которые позволили бы усовершенствовать идентификацию грибковой инфекции, дополнить или заменить классические методы. Поэтому, помимо рутинных микроскопического и культурального методов, активно изучаются новые возможности, такие как определение антигена Tr. verrucosum var. verrucosum методом иммуноферментного анализа, а также прямая ДНК-диагностика дерматомицетов. Молекулярно-биологические методики, такие как РСИ - RFLP, ПЦР реального времени и мультиплексный ПЦР, были адаптированы для определения дерматомицетов в клинических образцах. Эти молекулярные методы имеют хороший потенциал для прямого определения дерматомицетов, вместе с тем они еще нуждаются в стандартизации для обычных клинических лабораторий [1].
В 2004 году в России были разработаны и успешно применены в клинических условиях первые генетические зонды для прямой диагностики дерматофитии кожи, волос и ногтей. Данный проект был инициирован в 2003 году Национальной академией микологии с целью изучения возможности применения полимеразной цепной реакции (ПЦР) в выявлении Trichophyton rubrum в клинических образцах. Затем был создан аналогичный метод для Trichophyton mentagrophytes [15].
Лишь несколько авторов сравнивали в клинических образцах КОН-микроскопию и культивирование с ПЦР-методом. В исследовании Nagao и соавт. определили Trichophyton rubrum посредством «вложенной» ПЦР, имеющей мишенью ген внутреннего транскрибируемого спейсера 1 (ВТС1), который был негативен как по данным КОН-микроскопии, так и по данным культивирования. Yan и соавт. сравнили случайно праймируемую ПЦР с общепринятыми методами показали, что случайно праймируемая ПЦР - это более быстрый, чувствительный и специфичный метод для диагностики дерматофитий. Подобных исследований в отношении возбудителей трихофитии у собак не проводилось [28].
В соответствии с общими тенденциями, наблюдаемыми в сфере диагностики, ПЦР реального времени может в будущем стать заменой методам прямой микроскопии и культивирования. Высокая цена ПЦР на сегодняшний день и редкость применения этого метода в ветеринарных клиниках является лимитирующим фактором, но это может измениться в результате уменьшения цен на рынке реагентов и появлением сбережений, вызванных заменой общепринятой диагностики [6].
Таким образом, традиционные доступные методы лабораторной диагностики трихофитии у собак не всегда позволяют определить вид возбудителя и соответственно выбрать оптимальный метод лечения. Назревшая необходимость в методах быстрой и точной идентификации возбудителей открывает перспективы для внедрения в диагностику данного заболевания такого современного, высокочувствительного и специфичного метода исследования, как метод полимеразной цепной реакции [13].
После подтверждения диагноза трихофитии у собак с лечебной целью вводят 2- или 3- кратно вакцину против трихофитии. Одновременно назначают средства, обладающие фунгистатическими и фунгицидными свойствами. В начальном периоде болезни пораженные места обрабатывают раствором салициловой кислоты на 5%-й настойке йода, а также жидкостями и пастами, обладающими фунгицидными свойствами. Достаточно широко представлен ряд готовых фунгицидных форм: фунгин, нитрофунгин; мази: ундециновая, цинкундан, микосептин, «Ям», клотримазол, вединол, экалин, травоген; раствор «Никлофен», эпацид F, Апит. Смазывать или втирать в пораженные участки кожи 2-3 раза в день. Лечебный эффект усиливается при одновременном введении гризеофульвина или низорала. После выздоровления для ускорения роста волос в пораженные участки кожи втирают Carbolici cristall, Ricini и др. Ежедневно втирают в кожу больного животного для стимуляции роста волос [24].
Профилактика трихофитии у животных создает предпосылки для ликвидации трихофитии у человека. Поэтому меры борьбы направлены на выявление и изоляцию больных животных. Их помещают в специальные изоляторы, не чистят и лечат противогрибными средствами. Подстилку сменяют ежедневно, сжигая старую. При профилактике болезни проводят тщательную очистку и дезинфекцию щелочным формалином (500 г каустической соды, 5,5 л формалина и 94 л воды) стен, ограждений, станков, пола. Инструменты, используемые при лечении, следует хорошо дезинфицировать 30%-ной уксусной кислотой или 5%-ным раствором хлорамина. Подозрительных по заболеванию животных наблюдают или подвергают превентивному лечению. Также при профилактики трихофитии необходимо соблюдать гигиенические требования, обеспечивать животных витамином А [26].
При каждом случае заболевания собак возникает необходимость медицинского осмотра всех лиц, находящихся в контакте с животными, и членов их семей. Больных изолируют и лечат. Регулярно сменяют и подвергают дезинфекции постельное белье, а также принадлежности для стрижки и бритья, дети должны носить колпак. Активизируют санитарно просветительную работу среди населения, разъясняя опасность заражения от больных животных и людей и пути распространения болезни. Санитарное просвещение детей проводится в школах [19].
ГЛАВА 3. ИСТОРИЯ БОЛЕЗНИ ЩЕНКА С ДИАГНОЗОМ ТРИХОФИТИЯ
Клинический статус
1. Вид: собака
2. Пол: сука
3. Порода: французский бульдог
4. Дата рождения животного: 15.04.2012
4.1. Возраст: 3 мес.
5. Кличка: Марго
6. Окрас: Палевый
7. Владелец и адрес животного: Антонова К.П., Москва.
8. Дата поступления животного: 08.07.12
9. Диагноз предварительный: Трихофития
10. Диагноз заключительный: Трихофития
11. Дата исхода болезни: 18.07.12
Анамнез
1. Anamnesis vitae. Щенок 3-х месячного возраста, содержится в благоустроенной квартире. Кормление 3-х разовое; утро, обед, вечер. Примерный рацион щенка: мясо - 300 г/сут., крупа овсяная - 100 г/сут., картофель - 40 г/сут., капуста - 40 г/сут., морковь - 30 г/сут., творог - 200 г/сут. Выгул 3 раза в день по 15 минут.
2. Amamnesis morbi. По словам владелицы, щенок заболел 4 июля вечером, что проявилось в появлении слегка заметной сыпи на подбородке, затем произошло увеличение площади поражения, на коже образовалась красноватая корка, а также началось выпадение волос в месте поражения. 6 июля у щенка на пораженном месте образовалась лысина с четкими границами. Из под корки начал течь гной.
Клинический осмотр
1. Общее состояние - Status Praesens. Телосложение: правильное, соответствует породе. Конституция: плотная. Положение: естественное, стоячее. Темперамент: уравновешенный. Упитанность: хорошая.
2. Обследование кожи и шерстного покрова. Кожа сухая непигментированная, эластичная. Волосяной покров блестящий, прочно удерживается, расположен равномерно по всей поверхности тела, кроме пораженной. В области подбородка на коже присутствуют небольшие безволосые пятна округлой формы, покрытые чешуйками и корочками асбестово-серого цвета. Зуд выражен. Происходит небольшое нагноение волосяных мешочков.
3. Обследование лимфатических узлов. Подчелюстные, немного увеличены, подвижные, плотной консистенции, безболезненные, местная температура не повышена. Паховые - подвижны, безболезненны, овально-округлой формы, не увеличены.
4. Обследование слизистых оболочек. Слизистая оболочка конъюнктивы розового цвета, блестящая. Без повреждений. Слизистая рта бледно-розовая, пигментирована. Температура тела животного в прямой кишке на момент приема нормальная.
5. Сердечно-сосудистая система. При пальпации сердечная область безболезненная. Перкуссией определены следующие границы сердца: передняя - по переднему краю 3-го ребра; верхняя - по линии лопатко-плечевого сустава; задняя - до 7-го ребра. Абсолютная тупость сердца в 5 - 6-м межреберьях. При аускультации тоны сердца громкие, четкие, ясные. Артериальный пульс на внутренней стороне бедра ритмичный, равномерно наполнен, частота 100 уд/мин.
6. Дыхательная система. При исследовании носовой полости не обнаружены серозные истечения. Дыхание поверхностное, ритмичное, преобладает брюшной тип дыхания. Частота дыхания: 30 дых. дв./мин. Пальпацией области гортани и трахеи безболезненна.
7. Пищеварительная система. Аппетит снижен, прием корма и воды - свободный. Слизистая ротовой полости бледно-розового цвета, без повреждений. Язык влажный, розовый с белым налетом. Расположение зубов соответствует возрасту животного. Пальпация глотки безболезненна. Слюнные железы не увеличены, безболезненны. Форма живота симметричная. Брюшная стенка безболезненная, умеренно напряжена. При глубокой пальпации обнаруживается желудок. При пальпации области кишечника болезненность отсутствует, при перкуссии звук тимпанический.
Моторика кишечника умеренная, слышны перистальтические шумы. Кишечник безболезненный, умеренно наполнен. При пальпации печень не увеличена, безболезненна, при перкуссии звук тупой. Область печеночного притупления находится справа от 11-го до 13-го межреберья по линии маклока, слева в области 12-го межреберья. По словам владелицы при дефекации животное принимает естественную позу. Фекалии плотные без посторонних включений и слизи.
8. Мочеполовая система. Наружные половые органы собаки без патологических изменений, соответствуют возрасту и полу животного. Истечений из половых органов нехарактерных для животного не наблюдается. При глубокой пальпации обнаруживаются два тела бобовидной формы - почки, левая прощупывается лучше, вследствие более удобного расположения в области в углу левой подвздошной ямки. Болезненной реакции в области почек и мочевого пузыря не наблюдается. В целом при пальпации щенок ведет себя спокойно. По словам владелицы, мочеиспускание происходит в естественной для возраста и пола собаки позе. Моча прозрачная водянистая.
9. Исследования черепа и позвоночного столба. Череп правильной формы, симметричный, соответствует экстерьеру породы. Позвоночный столб без искривлений. При пальпации реберных и позвоночных отростков не обнаружено признаков остеомаляции или смещений. Хвост прямой купированнный. Последние ребра целые, плотные, без рахитозных четок; межреберные пространства ровные.
10. Нервная система. Общее состояние животного угнетенное. Координация движений правильная. Тактильная и болевая чувствительность сохранены.
11. Органы чувств. Постановка глаз правильная, без отклонений. Глазные среды чистые, зрачки слегка расширены, реакция зрачков на свет не замедлена. Помутнений роговицы нет. Радужная оболочка нормального карего цвета, насколько можно судить. Слух не ослаблен, наружные ушные раковины целостные, правильной формы, без покраснений. Неестественные истечения из слуховых отверстий отсутствуют.
Лабораторные исследования
- Общий анализ крови, общий анализ мочи.
Общий анализ мочи от 8.07.12. Цвет мочи соломенно-желтый. Белок отрицательно. Моча прозрачная. Эпителий (плоский) 1-2 в п/з. Лейкоциты 1-2 в п/з. Реакция кислая Уд. Вес 1010. Заключение: в пределах нормы.
Общий анализ крови от 8.07.12.
Эритроциты 4.5*1012 /л
Нb 134 г/л
ЦП 0,93
Лейкоциты 8,0*109
Нейтрофилы 7
Палочкоядерные 0
Сегментоядерные 61
Лимфоциты 29
Моноциты 3
СОЭ 10 мм/ч
Заключение: в пределах нормы.
2.Биохимический анализ крови.
Биохимический анализ крови от 8.07.12.
Общ. Белок 74 г/л
Билирубин общ. 19,4 мкмоль/л
Креатинин 0,08 мкмоль
Тимоловая проба 2,0 Ед
АСТ 14,8 ед/л
АЛТ 21,6 ед/л
Заключение: в пределах нормы.
3. Анализ на грибы пораженного участка кожи щенка.
Обнаружены грибы Trichophyton mentagrophytes var. gypseum.
4. Анализ кала на яйца глистов.
Яиц глистов не обнаружено.
Диагноз и его обоснование
На основании данных анамнеза и клинического исследования животного установлен диагноз: трихофития.
Прогноз лечения
При соблюдении всех пуктов плана лечения щенка, прогноз благоприятный ввиду своевременного обращения в лечебное учреждение и некоторой компетентности хозяина - собаковода со стажем.
План лечения
Лечение трихофитии комплексное. Для устранения этиологического фактора болезни животному необходимо создать оптимальные зоогигиенические условия содержания и кормления. С лечебной целью вводят 2- или 3- кратно вакцину против трихофитии. Одновременно назначают средства, обладающие фунгистатическими и фунгицидными свойствами. В начальном периоде болезни пораженные места обрабатывают раствором салициловой кислоты на 5%-й настойке йода, а также жидкостями и пастами, обладающими фунгицидными свойствами. Достаточно широко представлен ряд готовых фунгицидных форм: фунгин, нитрофунгин; мази: ундециновая, цинкундан, микосептин, «Ям», клотримазол, вединол, экалин, травоген; раствор «Никлофен», эпацид F, Апит. Смазывать или втирать в пораженные участки кожи 2-3 раза в день.
Лечебный эффект усиливается при одновременном введении гризеофульвина или низорала. После выздоровления для ускорения роста волос в пораженные участки кожи втирают Carbolici cristall, Ricini и др. Ежедневно втирают в кожу больного животного для стимуляции роста волос.
Рецепты
1. Rp.: Acidi salicylici 1,0
T-rae jodi spirituosae 5% 10,0
M.D.S. Наружное. Пораженные участки кожи и окружающие здоровые ткани смазывать несколько раз.
2. Rp.: Sol. Fuxini spirituosae 10,0 ml
Sol. Phenoli 5 % 100,0 ml
Ac. borici 1,0
Resorcini 10,0
Acetoni 5,0
M.D.S. Фунгицидное средство. Наносить на пораженные участки кожи (жидкость Кастеллани).
3. Rp.: Sol. Fungini 20 ml
D.S. Смазывать пораженные участки кожи 2-3 раза в день.
4. Rp.: Tab. Griseofulvini 0,125 N.40
D.S. Внутрь по 1 таблетке по 1 таблетке 2 раза в день - 1 неделю.
5. Rp.: 01. Ricini 25,0
Tannini 5,0
Spiritus aethylici 95 % 150, 0
Ol. Sinapis actherei 2,0
M.D.S. Ежедневно втирать в кожу для стимуляции роста волос.
Течение болезни
|
Дата |
t °C |
Пульс |
ЧД |
Симптомы |
Лечение |
|
8.07.12 |
37, 6 |
100 |
30 |
Угнетенное состояние, общая слабость, повы-шенная температура тела, увеличение регио-нарных лимфоузлов, снижение аппетита. В области подбородка на коже небольшие безво-лосые пятна округлой формы, покрытые че-шуйками и корочками асбестово-серого цвета. Зуд. Нагноение воло-сяных мешочков. |
Введение вакци-ны против три-хофитии. Сма-зывание пора-женных мест раствором сали-циловой кисло-ты на 5%-й настойке йода, а также фунгином и жидкостью Кастеллани 2 раза в день. Гризеофульвин внутрь по 1 таб. 2 раза в день. |
|
9.07.12 |
37,5 |
99 |
32 |
Угнетенное состояние, общая слабость, повы-шенная температура тела, увеличение регио-нарных лимфоузлов, снижение аппетита. В области подбородка на коже небольшие безво-лосые пятна округлой формы, покрытые че-шуйками и корочками асбестово-серого цвета. Зуд. Нагноение воло-сяных мешочков. Ухудшений не наблю-дается. |
Смазывание по-раженных мест раствором сали-циловой кисло-ты на 5%-й настойке йода, а также фунгином и жидкостью Кастеллани 2 р. в день. Гризео-фульвин внутрь по 1 таб. 2 раза в день. |
|
10.07.12 |
37,4 |
87 |
34 |
Угнетенное состояние, общая слабость, повы-шенная температура тела, увеличение регио-нарных лимфоузлов, снижение аппетита. В области подбородка на коже небольшие безво-лосые пятна округлой формы, покрытые че-шуйками и корочками асбестово-серого цвета. Зуд. Нагноение воло-сяных мешочков. Ухудшений не наблю-дается. |
Смазывание по-раженных мест раствором сали-циловой кисло-ты на 5%-й настойке йода, а также фунгином и жидкостью Кастеллани 2 р. в день. Гризео-фульвин внутрь по 1 таб. 2 раза в день. |
|
11.07.12 |
37,2 |
97 |
29 |
Угнетенное состояние, общая слабость, повы-шенная температура тела, увеличение регио-нарных лимфоузлов, снижение аппетита. В области подбородка на коже небольшие безво-лосые пятна округлой формы, покрытые че-шуйками и корочками асбестово-серого цвета. Зуд. Нагноение воло-сяных мешочков. Ухуд-шений не наблюдается. |
Смазывание по-раженных мест раствором сали-циловой кисло-ты на 5%-й настойке йода, а также фунгином и жидкостью Кастеллани 2 р. в день. Гризео-фульвин внутрь по 1 таб. 2 раза в день. |
|
12.07.12 |
37,3 |
94 |
30 |
Угнетенное состояние, общая слабость, повы-шенная температура тела, увеличение регио-нарных лимфоузлов, снижение аппетита. В области подбородка на коже небольшие безво-лосые пятна округлой формы, покрытые че-шуйками и корочками асбестово-серого цвета. Зуд не выражен. Нагноение волосяных мешочков уменьша-ется. Ухудшений не наблюдается. |
Смазывание по-раженных мест раствором сали-циловой кисло-ты на 5%-й настойке йода, а также фунгином и жидкостью Кастеллани 2 р. в день. Гризео-фульвин внутрь по 1 таб. 2 раза в день. |
|
13.07.12 |
37,2 |
85 |
31 |
Общее состояние улу-чшилось, температура тела снизилась, увели-чение регионарных лимфоузлов, снижение аппетита. В области подбородка на коже небольшие безволосые пятна округлой формы, покрытые чешуйками и корочками асбес-тово-серого цвета. Зуд не выражен. Нагное-ние волосяных ме-шочков уменьшается. Ухудшений не наблю-дается. |
Смазывание по-раженных мест раствором сали-циловой кисло-ты на 5%-й настойке йода, а также фунгином и жидкостью Кастеллани 2 р. в день. Гризео-фульвин внутрь по 1 таб. 2 раза в день. |
|
14.07.12 |
37,1 |
90 |
25 |
Общее состояние улу-чшилось, температура тела снизилась, увели-чение регионарных лимфоузлов, снижение аппетита. В области подбородка на коже небольшие безволосые пятна округлой формы, покрытые чешуйками и корочками асбес-тово-серого цвета. Зуд не выражен. Нагное-ние волосяных ме-шочков уменьшается. Ухудшений не наблю-дается. |
Смазывание по-раженных мест раствором сали-циловой кисло-ты на 5%-й настойке йода, а также фунгином и жидкостью Кастеллани 2 р. в день. Гризео-фульвин внутрь по 1 таб. 2 раза в день. |
|
15.07.12 |
37,1 |
88 |
28 |
Общее состояние улу-чшилось, температура тела снизилась, регио-нарные лимфоузлы уменьшились, аппетит улучшился. Зуд не выражен. Нагноение волосяных мешочков прекратилось. Шелу-шение пораженного участка уменьшилось. |
Смазывание по-раженных мест раствором сали-циловой кисло-ты на 5%-й настойке йода, а также фунгином и жидкостью Кастеллани 2 р. в день. Гризео-фульвин внутрь по 1 таб. 2 раза в день. |
|
16.07.12 |
37 |
94 |
30 |
Общее состояние удов-летворительное, собака подвижна, температура тела в норме, аппетит в норме. Зуда нет. Наг-ноение волосяных ме-шочков прекратилось. Шелушение не выра-жено. |
Смазывание по-раженных мест раствором сали-циловой кисло-ты на 5%-й настойке йода, а также фунгином и жидкостью Кастеллани 2 р. в день. Гризео-фульвин внутрь по 1 таб. 2 раза в день. |
|
17.07.12 |
36,9 |
99 |
30 |
Общее состояние в норме, собака под-вижна, температура те-ла в норме, аппетит в норме. Пораженные участки кожи восста-навливаются. |
Смазывание по-раженных мест раствором сали-циловой кисло-ты на 5%-й настойке йода, а также фунгином и жидкостью Кастеллани 2 р. в день. Гризео-фульвин внутрь по 1 таб. 2 раза в день. |
|
18.07.12 |
36,9 |
98 |
29 |
Общее состояние в норме, собака под-вижна, температура те-ла в норме, аппетит в норме. Пораженные участки кожи восста-навливаются. |
Смазывание по-раженных мест раствором сали-циловой кисло-ты на 5%-й настойке йода, а также фунгином и жидкостью Кастеллани 2 р. в день. Гризео-фульвин внутрь по 1 таб. 2 раза в день. |
После выздоровления для ускорения роста волос в пораженные участки кожи необходимо втирать Carbolici cristall, Ricini и др. Ежедневно втирают в кожу больного животного для стимуляции роста волос.
Рис. 4. График температуры, пульса и частоты дыхания щенка с трихофитией в дни протекания болезни.
Эпикриз
Трихофития - распространенное среди дерматомикозов собак заболевание, основными возбудителями которой являются Trichophyton verrucosum и Trichophyton mentagrophytes var. gypseum. Трихофития у собак встречается чаще чем другие дермофитии. Болеют обычно щенки, плохо питающиеся собаки, а также животные с пониженным за счет другого заболевания иммунитетом. Источником возбудителя являются больные и переболевшие животные. Это кожное заболевание передается собакам от других животных через поврежденные участки кожи, путем контакта со спорами, находящимися в земле, на игрушках и мебели.
Больная собака, французский бульдог, сука, 15.04.2012 г.р. находится на лечении с 08.07. по 18.07. 2012 года с диагнозом: нагноительная трихофития подбородка (1 очаг). При поступлении владелица собаки предъявила жалобы на появление у щенка слегка заметной сыпи на подбородке, затем произошло увеличение площади поражения, на коже образовалась красноватая корка, а также началось выпадение волос в месте поражения. 6 июля у щенка на пораженном месте образовалась лысина с четкими границами. Из под корки начал течь гной.
Проведено обследование: физикальное, анализ на грибы, ОАК, ОАМ, БХ крови.
Проведено лечение: введена вакцина против трихофитии. Пораженные места в течение 10 дней обрабатывались раствором салициловой кислоты на 5%-й настойке йода, а также фунгином и жидкостью Кастеллани 2 раза в день. Одновременно вводился гризеофульвин внутрь по 1 таб. 2 раза в день. После выздоровления для ускорения роста волос в пораженные участки кожи рекомендовано втирание Carbolici cristall или Ricini ежедневно.
Заболевание у щенка протекало с типичными клиническими признаками. Назначенное лечение оказало должный эффект, т.к. выздоровление наступило в минимальные сроки. Рекомендуется более расширенный рацион и более полноценное питание.
ЗАКЛЮЧЕНИЕ
Трихофития - (Trichophytosis), трихофитоз, стригущий лишай, инфекционная болезнь животных и человека, вызываемая несовершенными грибами рода Trichophyton, характеризующаяся у животных появлением на коже участков с обломанными волосами, покрытых корками и чешуйками. Распространена в большинстве стран мира, в том числе и в России.
Т. verrucosum вызывает главным образом трихофитию крупного рогатого скота, зебу, буйволов, верблюдов, реже серебристо-чёрных лисиц, песцов. T. mentagrophytes (gypseum) - основной возбудитель трихофитии собак, кроликов, серебристо-чёрных лисиц, песцов, мышей-полёвок, сусликов, а также зверей, содержащихся в зоопарках, питомниках и др.[17].
Трихофитией болеют животные всех видов и возрастов. Источники инфекции - больные и переболевшие животные. Факторы передачи - инфицированные помещения, инвентарь. Мышевидные грызуны - постоянный резервуар T. mentagrophytes в природе. Инфицированные возбудителями трихофитии сено, солома, пух, волос, шерсть служат источником заражения кроликов, пушных зверей, крупного рогатого скота, овец, лошадей. Микротравмы способствуют внедрению возбудителя. В зверохозяйствах, кролиководческих комплексах, откормочных совхозах, питомниках, где концентрируется большое поголовье животных, трихофития может протекать как энзоотия [21].
Переболевшие трихофитией животные приобретают длительный напряжённый иммунитет. Показатели серологических реакций (РА, РСК) сохраняются лишь 2-3 месяца, через 6-8 месяцев они могут полностью угаснуть. При поверхностной трихофитии заражение людей (особенно часто детей) происходит при контакте с больным животным и через инфицированные предметы. На коже появляются округлые розовые пятна с чёткими приподнятыми краями и шелушением в центре. В очагах на волосистой части головы волосы разрежены и обломаны. Поражённые ногти - грязно-серые, тусклые, неровные, края их утолщены, крошатся. Глубокая трихофития возникает при заражении грибами, паразитирующими у животных (особенно опасны больные трихофитией пушные звери, собаки, кролики и кошки). Отмечают воспалительные нагноившиеся узлы с корками на поверхности, облысение [35].
СПИСОК ЛИТЕРАТУРЫ
- Авилов В.М. Ветеринария. - СПб.: Питер, 2006. - 338 с.
- Азаров В.Н. Основы микробиологии и санитарии. - М.: Экономика, 1996. - 205 с.
- Антонов В.Б., Медведева Т.В., Леина Л.М. и др. К вопросу об инфильтративно-нагноительной трихофитии // Успехи медицинской микологии. Т. 8. - М.: Национальная академия микологии, 2006. - С. 185 -187.
- Астраханцев В.И. Болезни собак. - М.: Колос, 2001. - 258 с.
- Белов Е.П. Болезни собак. - М.: Агропромиздат, 1990. - 368 с.
- Борисов Л.Б. Медицинская микробиология, вирусология, иммунология.- М.: Медицинское информагенство, 2005.- 735 с.
- Воробьев А.А. Медицинская и санитарная микробиология.- М.: Академия, 2003.- 462 с.
- Ветеринарная лабораторная медицина. Интерпретация и диагностика: [собаки, кошки, лошади, жвачные животные, свиньи]. Мейер Д., Харви Дж. М.: Софион, 2007.- 458 с.
- Глотова Т. И. Дерматомикозы собак и кошек в условиях города//Ветеринария, 1998, № 1. С. 59-61.
- Гинзбург А.Г. Организация и планирование ветеринарного дела. - М.: Аспект-Пресс, 2005. - 492 с.
- Гусев М.В. Микробиология. - М.: Академия, 2009. - 464 с.
- Евсеенко К.А. Новые горизонты медицинской микологии// Мед. новости. - 2003. - Т. 12. - С. 4-9.
- Кашкин П. H, Лисин В. В. Практическое руководство по медицинской микологии. - Л.: Медицина, 1990. -195 с.
- Kyxap E.В. Поиск антигенов для ИФА-диагностики зооантропонозной трихофитии // Проблемы мед. микол. - 2007. - Т. 2. - С. 73 - 74.
- Лещенко П. Н. Лабораторная диагностика грибковых заболеваний. - М.: Медицина, 1987. 146 с.
- Литвинов A.M. Дерматофитозы кошек и собак (профилактика и лечение)//Ветеринария. № 11, 2000. С.51-53.
- Луферов А.Ф. Методические рекомендации по оздоровлению домашних очагов зооантропонозной микроспории и трихофитии. Минск: Высшая школа. 1998. - 15 с.
- Лысак В.В. Микробиология. - Минск: БГУ, 2007. - 426 с.
- Медведева Г. В., Антонов В. Б., Леина Л. М. и др. Трихофития: современные представления об этиологии, клинической картине, особенностях диагностики и терапии // Клин. дерматол. и венерол. - 2007. - Т. 4. - С. 70 - 74.
- Медведев К.С. Болезни кожи собак и кошек / К.С. Медведев. Киев: ВИМА, 1999.-218 с.
- Медицинская микробиология. / Под ред. А.М. Королюка, С.Б. Стойчакова. - СПб.: ЭЛБИ, 2002.- 267 с.
- Микробиология и иммунология. / Под ред. А.А. Воробьева.- М.: Медицина, 2005.- 492 с.
- Минеева Л.А. Микробиология. - М.: Академия, 2010. - 464 с.
- Нуралиев М.Д. Эпидемиология, особенности клиники и совершенствование терапии трихофитии в условиях жаркого климата. - Душанбе, 2007.- 200 с.
- Организация и экономика ветеринарного дела / Под ред. А.Д. Третьякова. - М.: Проспект, 2001. - 260 с.
- Основы микробиологии, вирусологии и иммунологии. / Под ред. Ю.С. Кривошеина.- М.: Высшая школа, 2001.- 224 с.
- Петрович С.В. Микозы животных. М.: Росагропромиздат. - 1989. - 173 с.
- Райкис Б. Общая микробиология с вирусологией и иммунологией. - М.: Триада - Х, 2002.- 347 с.
- Саркисов А.Х. Диагностика грибных болезней животных/А.Х. Саркисов, В.П. Королева, Е.С. Квашнина, В.Ф. Грезин//М.: Колос. - 1971. - 144 с.
- Справочник ветеринарного врача / Под ред. Н.М. Алтухова. - М.: Колос, 1996. - 352 с.
- Степанова Ж.В., Гребенюк В.Н., Воробьева И.А. и др. Диагностические ошибки при зооантропонозной трихофитии // Вестн. дерматол. - 2001. - Т. 6. - С. 36-38.
- Федюк В.И. Справочник болезней собак и кошек.- М: Академия. - 2001. - 338 с.
- Хисматуллина 3. Р. Мухамадеева О. Р. Способ выделения дерматофитов//Вестн. дерматол. - 2006. - Т. 2. - С. 25-27.
- Хисматуллина З.Р., Фахретдинова X. С, Мухамадеева О.Р. Зооантропонозная трихофития. - Уфа: Башкириздат, 2004. 125 с.
- Arabatzis М, Bruijnesteijn van Coppenraet L.E. S., Kuijper E.J. et al. Diagnosis of common dermatophyte infections by a novel multiplex real-time polymerase chain reaction detection/identification scheme // Br. J. Dermatol. - 2007. - Vol. 157.-P. 681-689.
- Jennings M.B., Rinaldi M.G. Confirmation of dermatophytes in nail specimens using in-office dermatophyte test medium cultures. Insights from a multispecialty survey //J. Am. Podiatr. Med. Assoc. - 2003. - Vol. 93, №3. - P. 195-202.
- Rippon J. W. Medical mycology // The Pathogenic Fungi and the Pathogenic Actinomycetes 3rd ed. - Philadelphia: WB Saunders, 1988.
- WeinbergJ.M., KoestenblattE.K., Tutrone W.D. etal Comparison of diagnostic methods in the evaluation of onychomycosis // J.Am. Acad. Dermatol. - 2003. - Vol. 49, №2. - P. 193-197.
- Yang G., Zhang M., Li W. et al Direct species identification of common pathogenic dermatophyte fungi in clinical specimens by semi-nested PCR and restriction fragment length polymorphism //Mycopathologia. - 2008. - Vol. 166, №4. - P. 203-208.
- Yan D. Detection of fungiinliquor workers with tinea corporis and tinea cruris using arbitrarily primed polymerase chain reaction // Zhonghua Lao Dong Wei Sheng Zhi Ye Bing Za Zhi. - 2007. - Vol. 25, №3. - P. 133-135.
PAGE \* MERGEFORMAT 3
Стригущий лишай (трихофития) у собак